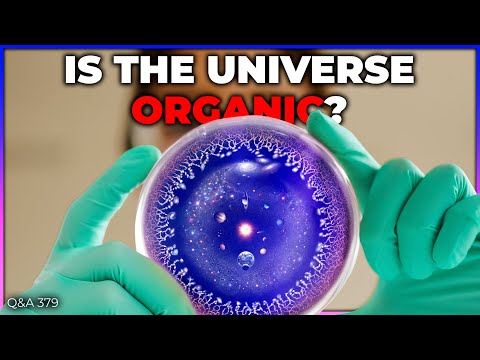

It's already been two years of JWST operations. In this episode we accumulated all the major science results, all the amazing images and graphs, all the important discoveries and controversies. Enjoy the ULTIMATE GUIDE to the second year of James Webb. 🥇 All the JWST discoveries from YEAR 1 🦄 Support us on Patreon: 📚 Suggest books in the book club: 00:00 Intro 01:29 Jupiter's Moons 04:26 Uranus and its faintest rings 05:58 Exoplanets 06:24 TRAPPIST-1 system 09:04 Exomoon around a brown dwarf 11:01 Asteroid collisions 12:15 Hycean world 16:00 Methane on an exoplanet 17:00 Exoplanet weather 19:15 Water delivery to exoplanets 20:33 Sand clouds on an exoplanet 22:00 Rogue planets 24:12 Key molecule for life 25:53 Lobster nebula 27:07 A very young star 28:11 Horsehead nebula 29:24 Binary young star 30:40 Ring nebula 31:52 Pillars of creation in 3D 33:05 Crab nebula 34:02 Cassiopea A 34:49 Heart of the Milky Way 36:02 Extragalactic 36:19 Supernova 1987a 37:51 Triangulum galaxy 39:38 Spiral galaxies face on 40:51 Whirlpool galaxy 42:21 El Gordo and gravitational lenses 43:45 Erindel 45:08 Cosmic web 46:19 Most distant active black hole 48:16 Most distant galaxy 49:25 Epoch of Re-ionization 51:24 What's next Host: Fraser Cain Producer: Anton Pozdnyakov Editing: Artem Pozdnyakov Video and Images Credit: NASA 📰 EMAIL NEWSLETTER Read by 60,000 people every Friday. Written by Fraser. No ads. Subscribe Free: 🎧 PODCASTS Universe Today: Astronomy Cast: 🤳 OTHER SOCIAL MEDIA Twitter: Twitter: Facebook: Instagram: 📩 CONTACT FRASER frasercain@ ⚖️ LICENSE Creative Commons Attribution 4.0 International (CC BY 4.0) You are free to use my work for any purpose you like, just mention me as the source and link back to this video.